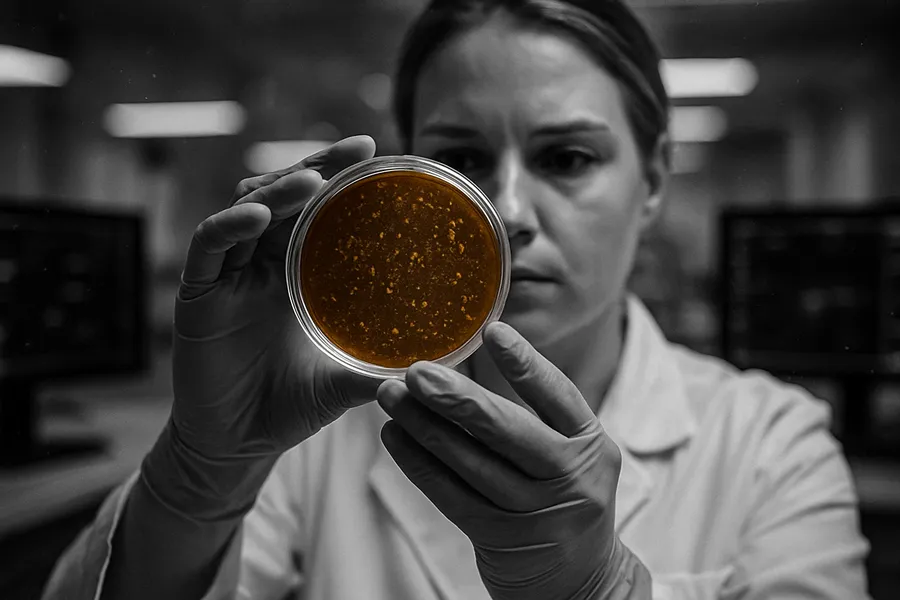

Regenxbio Inc (RGNX.O) said Wednesday its experimental gene therapy for Duchenne muscular dystrophy showed continued muscle function improvements in early-stage trial data. The results support the company’s plan to file for accelerated FDA approval by mid-2026, potentially offering new hope for patients with the rare degenerative muscle disease.
Key Takeaways
- RGX-202 patients exceeded natural history controls on all measures
- No serious adverse events reported in ongoing trial
- FDA approval filing planned for mid-2026 via accelerated pathway
Market reaction & context
The biotech company’s RGX-202 therapy demonstrated consistent improvements in muscle function tests compared to external natural history controls in the Phase I/II AFFINITY DUCHENNE trial 1. At nine months post-treatment, patients showed an average four-point improvement on the North Star Ambulatory Assessment and maintained gains at 12 months.
Duchenne muscular dystrophy affects one in 3,500 to 5,000 boys born annually worldwide, representing a significant unmet medical need in the rare disease space. The progressive muscle-wasting condition typically leads to loss of mobility by adolescence and premature death from respiratory or cardiac complications.
Clinical data details
The interim data from five participants aged six to 12 years showed RGX-202 recipients improved 4.5 points from baseline on muscle function assessments at 12 months. More notably, they exceeded natural history controls by 6.8 points on average 1.
Biomarker analysis revealed robust microdystrophin expression levels, with one patient aged two years at dosing showing 118.6% expression compared to normal controls. The therapy also demonstrated the highest reported vector genome copies across approved or investigational gene therapies in this indication 1.
Safety profile and differentiation
RGX-202 maintained a clean safety profile with no serious adverse events or adverse events of special interest reported. Common drug-related side effects included nausea, vomiting and fatigue, typically expected with gene therapy administration 1.
The treatment uses a differentiated microdystrophin construct that includes the C-Terminal domain found in naturally occurring dystrophin. Preclinical studies showed this domain protects muscle from contraction-induced stress and improves repair capability, potentially offering superior durability compared to competing approaches 2.
Management outlook
“Today’s findings support the potential of RGX-202 to positively change the disease course for Duchenne and meaningfully benefit patients living with this degenerative disease,” said Steve Pakola, chief medical officer at Regenxbio 1. The company expects to complete pivotal trial enrollment in 2025 and submit its biologics license application by mid-2026.
The pivotal portion of the AFFINITY DUCHENNE trial is enrolling approximately 30 ambulatory patients aged one year and older across the US and Canada. More than half have already enrolled to support the pivotal dataset 1.
Competitive landscape
RGX-202 represents the only gene therapy approved or in late-stage development for Duchenne that includes the C-Terminal domain, making it closest to naturally occurring dystrophin. This differentiation could prove crucial in a competitive landscape where several companies are pursuing similar gene replacement strategies.
The accelerated approval pathway allows FDA authorization based on biomarker endpoints that reasonably predict clinical benefit, potentially shortening the timeline to market for patients with limited treatment options.
Not investment advice. For informational purposes only.
References
1(June 5, 2025). “REGENXBIO REPORTS NEW POSITIVE FUNCTIONAL DATA FROM PHASE I/II AFFINITY DUCHENNE® TRIAL OF RGX-202”. Regenxbio Inc. Retrieved March 11, 2026.
2(July 10, 2025). “REGENXBIO Announces Publication of Preclinical Results Demonstrating Functional Benefits of Novel Microdystrophin Construct in RGX-202”. Regenxbio Inc. Retrieved March 11, 2026.
3(March 19, 2025). “REGENXBIO REPORTS POSITIVE BIOMARKER DATA FROM AFFINITY DUCHENNE® TRIAL OF RGX-202 GENE THERAPY”. Regenxbio Inc. Retrieved March 11, 2026.
4(November 18, 2024). “REGENXBIO Initiates Pivotal Phase of AFFINITY DUCHENNE® Trial of RGX-202 Gene Therapy, Reports Positive Functional Data”. Parent Project Muscular Dystrophy. Retrieved March 11, 2026.